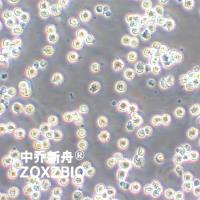
Burkitts淋巴瘤细胞系

相关产品推荐更多 >
万千商家帮你免费找货
0 人在求购买到急需产品
- 详细信息
- 文献和实验
- 技术资料
- 英文名:
Caov-3
- 库存:
100
- 供应商:
中乔新舟
- 运输方式:
常温
- 年限:
液氮长期
- 生长状态:
贴壁生长
- 规格:
T25
|
产品名称 |
Caov-3人卵巢腺癌细胞 |
|
货号 |
ZQ0484 |
|
产品介绍 |
Caov-3细胞系是一种源自人类卵巢腺癌的癌细胞系,它在1976年首次从一位54岁白人女性的卵巢腺癌组织中被分离并建立。这些细胞具有类似于上皮细胞的形态,并在实验室培养条件下能够形成密集的细胞菌落,模拟原发性卵巢癌的细胞行为。在遗传学上,Caov-3细胞展示了p53基因的一个无义突变,以及PIK3CA基因的多个拷贝,后者是一个与卵巢癌相关的癌基因。这些细胞表现出明显的致瘤性,即它们能够在宿主体内形成肿瘤,并且对几种常用的化疗药物,包括长春碱、顺铂和阿霉素表现出敏感性。尽管Caov-3细胞不能在软琼脂中生长,它们仍然能够在免疫功能受损的小鼠体内引起癌症,这使得它们成为3D细胞培养实验的理想选择。作为一个研究工具,Caov-3细胞系对于理解卵巢癌的生物学基础和发展新的治疗策略至关重要。通过使用这些细胞进行研究,科学家们可以探索疾病的复杂机制,并测试新的治疗方法。 注意事项:该细胞贴壁较慢,请于贴壁48小时后再进行观察或后续操作。 caov-3细胞胞体上有黑色颗粒,并且分泌少量黑色颗粒是正常现象。 |
|
种属 |
人 |
|
性别/年龄 |
女/54岁 |
|
组织 |
卵巢 |
|
疾病 |
腺癌 |
|
细胞类型 |
肿瘤细胞 |
|
形态学 |
上皮的 |
|
生长方式 |
贴壁 |
|
倍增时间 |
大约44~78小时 |
|
培养基和添加剂 |
DMEM高糖(中乔新舟 货号:ZQ-100)+10%胎牛血清(中乔新舟货号:ZQ0500)+1%双抗(中乔新舟货号:CSP006)+1% Sodium Pyruvate 100 mM Solution(中乔新舟货号:CSP003) |
|
推荐完全培养基货号 |
ZM0484 |
|
生物安全等级 |
BSL-1 |
|
STR位点信息 |
Amelogenin: X CSF1PO: 10,13 D13S317: 12 D16S539: 9 D5S818: 12 D7S820: 10 THO1: 7 TPOX: 8,10 vWA: 16,18 |
|
培养条件 |
95%空气,5%二氧化碳;37℃ |
|
抗原表达/受体表达 |
*** |
|
基因表达 |
*** |
|
保藏机构 |
ATCC; HTB-75 |
|
供应限制 |
仅供科研使用 |
上海中乔新舟生物科技有限公司成立于2011年,历经十多年发展,主要专注于细胞生物学产品的研究和开发,专注于为药企、各类科研机构及CRO企业提供符合标准规范的细胞培养服务、细胞培养基、细胞检测试剂盒、细胞培养试剂,胎牛血清和细胞生物学技术服务等。
公司一直致力于为高等院校、研究机构、医院、CRO及CDMO企业提供细胞培养完整解决方案,这些产品旨在满足细胞培养的多样需求,确保实验和研究的有效进行。引用中乔新舟(ZQXZBIO)产品和服务的文献超数千篇。

产品服务
细胞资源:原代细胞、细胞株、干细胞、示踪细胞、耐药株细胞、永生化细胞等基因工程细胞。
试剂产品:胎牛血清、完全培养基(适用于原代细胞及细胞株)、无血清培养基、基础培养基、细胞转染试剂、重组因子、胰酶和双抗等等细胞培养所有实验相关产品。
技术服务:稳转株构建、原代细胞分离、特殊培养基定制服务、细胞检测等。

目前产品已经畅销国内30多个省市,与客户建立长期的合作伙伴关系,共同实现成功。全体员工将不懈努力,继续为科研人员提供优良的产品和服务,致力成为全球细胞培养领域的参与者。

企业愿景
致力于成为国内细胞培养基产业的佼佼者,生物医药领域上游原材料的优良提供商。
企业使命
成长为专业细胞系及原代细胞培养供应商、专业细胞培养基及培养试剂生产商。
企业荣誉


风险提示:丁香通仅作为第三方平台,为商家信息发布提供平台空间。用户咨询产品时请注意保护个人信息及财产安全,合理判断,谨慎选购商品,商家和用户对交易行为负责。对于医疗器械类产品,请先查证核实企业经营资质和医疗器械产品注册证情况。
文献和实验论文标题: Six-transmembrane epithelial antigen of the prostate 1 expression promotes ovarian cancer metastasis by aiding progression of epithelial-to-mesenchymal transition
DOI: 10.1007/s00418-020-01877-7
发表时间: 2020-05-07
期刊: HISTOCHEMISTRY AND CELL BIOLOGY
影响因子: 4.304
货号: ZQ0484
产品名称: CAOV-3 cells
移植动物模型肿瘤生长及转移速度较快,可用来评价乳腺癌发生发展及转移过程中免疫应答的作用。异种移植一般采用人源组织或细胞接种于免疫缺陷小鼠(如重度免疫缺陷鼠 NCG),能模拟人恶性肿瘤成瘤后过程,可用于基础和临床研究。但人乳腺癌存在不同的分子分型,且人乳腺癌细胞系相对于其他癌种成瘤难度更大,且不稳定,因此选择合适的细胞系也十分重要。针对乳腺癌不同的分子分型,集萃药康细胞资源库配备丰富的乳腺癌细胞株以及热门靶点人源化改造的细胞资源,用于构建乳腺癌移植瘤模型。 表 1. 部分集萃药康乳腺癌细胞资源展示
LightCycler通过实时荧光PCR技术进行DNA甲基化分析
”和“HRM基因扫描”软件模块分析的数据。(b)含100%甲基化和非甲基化质控品和50%、25%、10%、5%和1%的甲基化标准品的MGMT MS-HRM测定法。使用“Tm Calling”和“HRM基因扫描”软件模块分析的数据。 图2:(a)FANCF MS-HRM测定,显示稀释卵巢癌细胞株2008中存在DNA甲基化。(b)MGMT MS-HRM测定,显示乳腺癌细胞株MDA-MB435和HS578T中存在甲基化。 结果和讨论 针对两个基因的MS-HRM测定法都可检出非甲基化DNA背景下1%的甲基
显示有些 PD-L1 诊断抗体并不特异[6],作者分别使用 PD-L1 28-8 和 C 公司 PD-L1 诊断抗体,对野生型和敲除的人肺腺癌细胞系 L2987 和人卵巢透明细胞癌细胞系 ES-2 的石蜡切片进行了 IHC 染色:在其他条件保持一致的情况下, 两种抗体(2 ug/mL)在 L2987 的 KO 细胞中均未检出信号(图 1A-D);28-8(3 ug/mL)在 ES-2 的 KO 细胞中未检测到信号,但 C 公司 PD-L1 诊断抗体(2 ug/mL)却呈现了非特异的胞浆染色(图 1E
技术资料暂无技术资料 索取技术资料